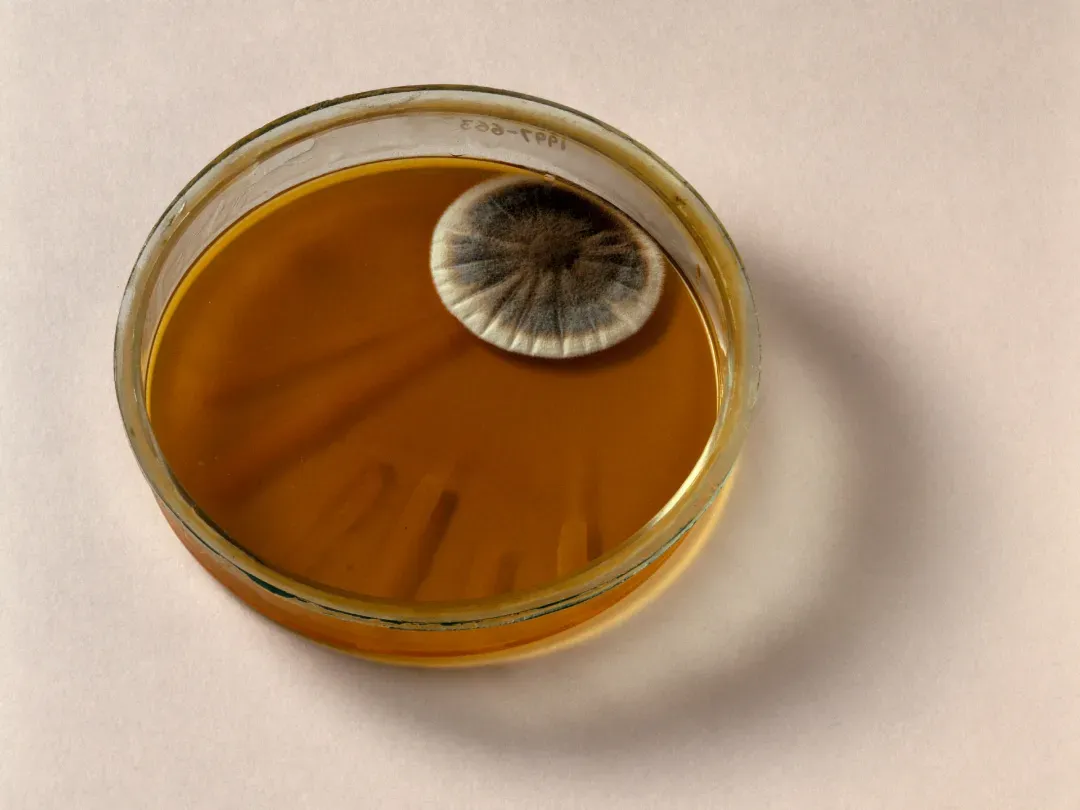
پنی سیلین

پنی سیلین چگونه کشف شد؟
صبح یک روز پاییزی در سال ۱۹۲۸، دانشمندی شلخته بهطور اتفاقی با کپکی عجیب در آزمایشگاهش روبرو شد. این کشف اتفاقی، مسیر پزشکی را برای همیشه دگرگون کرد.

صبح یک روز پاییزی در سال ۱۹۲۸، دانشمندی شلخته بهطور اتفاقی با کپکی عجیب در آزمایشگاهش روبرو شد. این کشف اتفاقی، مسیر پزشکی را برای همیشه دگرگون کرد.
به گزارش زومیت، ۲۸ سپتامبر ۱۹۲۸، صبح در لندن تازه از راه رسیده و الکساندر فلمینگ، فیزیکدان و میکروبشناس اسکاتلندی، پس از دو هفته تعطیلات به آزمایشگاه کوچک و بههمریختهاش در بیمارستان بازگشته بود. روی میزش، دهها ظرف پتری (ظروف کشت آزمایشگاهی) رها شده بودند که میراثی از عادت همیشگی او به انباشتن آزمایشها پیش از دور ریختنشان بود.
فلمینگ که صبح زود از خواب برخاست تا آزمایشهایش دربارهی رشد باکتریها را بررسی کند، نمیدانست که قرار است یکی از بزرگترین کشفیات تاریخ پزشکی را رقم بزند: نخستین آنتیبیوتیک جهان.
فلمینگ کارهایش را در اتاقی کوچک و تنگ، حدود یک متر مربع، در برجی از بیمارستان سنت مری لندن انجام میداد. او به بینظمی شهرت داشت و اغلب ظروف حاوی باکتریهای بیماران عفونی را برای هفتهها روی میز رها میکرد تا تعدادشان به ۴۰ یا ۵۰ عدد برسد. سپس، تکتک آنها را بررسی میکرد تا ببیند آیا چیز تازه یا غیرمعمولی در آنها رشد کرده است یا خیر و سپس، ظرفها را دور میانداخت.
آن روز صبح ناگهان در میان آشفتگی، چیزی عجیب چشمش را گرفت: کپک سبز ناخواندهای که روی یکی از ظروف پتری کشت باکتری استافیلوکوک اورئوس جا خوش کرده بود.
یک ظرف پتری که حاوی کلونیهای باکتریایی است و کپک P. notatum در گوشه بالا سمت راست آن رشد میکند. ماده شیمیایی تولید شده توسط این قارچ، اساس داروی پنیسیلین را تشکیل میدهد.
ظرف پتری که حاوی کلونیهای باکتریایی است و کپک پنیسیلیوم در گوشهی بالای سمت راست آن رشد میکند.
کپک سبز ناخوانده یک اتفاق عادی نبود. فلمینگ با دقت بیشتری نگاه کرد و متوجه هالهای شفاف در اطراف کپک شد. در آن محدوده، باکتریهای زرد طلایی که از یک زخم عفونی جدا شده بودند، گویی محو شده و مرده بودند. این دانشمند که به نامرتبی شهرت داشت، ناخواسته صحنهی یکی از بزرگترین اکتشافات تاریخ پزشکی را فراهم ساخت. آن «شیرهی کپک» مرموز، مادهای بود که بعدها پنیسیلین نام گرفت، ناجی جان میلیونها نفر شد و جهان را متحول کرد.
دانشمندی که به نامرتبی شهرت داشت، ناخواسته صحنه یکی از بزرگترین اکتشافات تاریخ پزشکی را فراهم ساخت
بهنقلاز لایوساینس، وی. دی. الیسون، دستیار فلمینگ، بعدها نوشت فلمینگ همان لحظه متوجه شد مادهای ناشناخته از کپک باکتریها را نابود کرده است؛ مادهای که بعدها اساس نخستین آنتیبیوتیک شد، هرچند اصطلاح «آنتیبیوتیک» تا سال ۱۹۴۱ وارد زبان علمی نشد. سالها بعد، فلمینگ در این باره گفت: «وقتی سپیدهدم ۲۸ سپتامبر ۱۹۲۸ از خواب بیدار شدم، قطعاً قصد نداشتم با کشف اولین آنتیبیوتیک یا قاتل باکتریها، در دنیای پزشکی انقلاب کنم. اما گمان میکنم دقیقاً همین کار را کردم.»
کشف تصادفی که یک دهه بعد جهانی شد
فلمینگ دریافت که شیرهی کپک از قارچی به نام پنیسیلیوم سرچشمه میگیرد. وقتی سال بعد کشف خود را برای همکاران پزشکش شرح داد، تقریباً هیچکس توجهی نکرد. جداسازی این ماده نیز بهشدت دشوار بود و همین باعث شد کشف فلمینگ نزدیک به یک دهه نادیده گرفته شود.
در سال ۱۹۳۹، هاوارد فلوری و ارنست چین به موضوع علاقهمند شدند. آنها تیمی تحقیقاتی تشکیل دادند و با همکاری دانشمندانی مانند مارگارت جنینگز، ادوارد آبراهام و نورمن هیتلی، توانستند با جداسازی پنیسیلین از کپک، آن را آزمایش کنند و با پودر زردرنگی که به دست آورده بودند، چند بیمار را درمان کنند. با اینحال، دارو هنوز خلوص کافی نداشت.
تا سال ۱۹۴۵، نخستین آنتیبیوتیک جهان بهطور وسیع در دسترس عموم قرار گرفت.
در سال ۱۹۴۲، فلمینگ پسر جوانی را که به مننژیت مبتلا بود، با استفاده از پنیسیلین درمان کرد. او با تماس با فلوری و چین مقداری پنیسیلین نیمهخالص دریافت کرد و آن را به نخاع بیمار تزریق نمود. نتیجه شگفتانگیز بود: بیمار بهبود یافت.
نجات یک زندگی، نقطه عطف تولید انبوه و افتخارات علمی
بهبودی معجزهآسای پسر بیمار مبتلا به مننژیت، فلمینگ را متقاعد کرد که پنیسیلین باید بهصورت انبوه تولید شود. او پیشنهاد تولید گسترده را به دولت ارائه داد و خیلی زود همکاری مشترکی میان آمریکا و بریتانیا برای تولید انبوه شکل گرفت. سرانجام تا سال ۱۹۴۵، نخستین آنتیبیوتیک جهان بهطور وسیع در دسترس عموم قرار گرفت.
پنیسیلین تاکنون جان حدود ۵۰۰ میلیون نفر را نجات داده است
در همان سال، فلمینگ، فلوری و چین به پاس کشف، جداسازی و تولید پنیسیلین جایزه نوبل پزشکی دریافت کردند. سالها بعد، در سال ۱۹۶۴، دوروتی هاجکین نیز به دلیل تعیین ساختار بلوری پنیسیلین و فراهم کردن امکان طراحی آنتیبیوتیکهای تازه، جایزه نوبل شیمی را به دست آورد.
برآورد میشود که از زمان کشف تاکنون، پنیسیلین جان حدود ۵۰۰ میلیون نفر را نجات داده است. این دارو و مشتقاتش همچنان ستون اصلی درمان بسیاری از بیماریها، مانند عفونت گوش، گلودرد استرپتوکوکی و عفونتهای ادراری محسوب میشوند.
همچنین، پنیسیلین راه را برای ساخت صدها آنتیبیوتیک دیگر نیز باز کرد. با اینحال، استفاده گسترده و گاه نادرست از این داروها موجب شد برخی باکتریها در برابر آنتیبیوتیکهای رایج، از جمله پنیسیلین، مقاوم شوند.
اکنون، دانشمندان در نبرد با ابرباکتریها، به دنبال روشهای نوینی هستند که بهرهگیری از ویروسها برای حمله به باکتریها و تا استفاده از فناوری ویرایش ژن CRISPR برای ساخت داروهای تازه را شامل میشود. اما فصل اول این داستان ناتمام، در آزمایشگاهی بههمریخته و با یک کپک شانسی نوشته شد.

